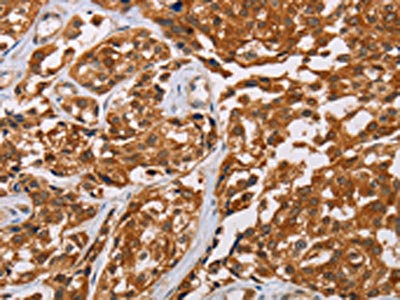

CRYAB Antibody
-
中文名稱:CRYAB兔多克隆抗體
-
貨號:CSB-PA098689
-
規(guī)格:¥1100
-
圖片:
-
The image on the left is immunohistochemistry of paraffin-embedded Human esophagus cancer tissue using CSB-PA098689(CRYAB Antibody) at dilution 1/20, on the right is treated with fusion protein. (Original magnification: ×200)
-
Gel: 12%SDS-PAGE, Lysate: 40 μg, Lane 1-3: Mouse heart tissue, human chromaffin cell tumor tissue, mouse muscle tissue, Primary antibody: CSB-PA098689(CRYAB Antibody) at dilution 1/500, Secondary antibody: Goat anti rabbit IgG at 1/8000 dilution, Exposure time: 1 minute
-
-
其他:
產(chǎn)品詳情
-
Uniprot No.:
-
基因名:
-
別名:AACRYA antibody; Alpha B crystallin antibody; Alpha crystallin B chain antibody; Alpha(B)-crystallin antibody; Alpha-crystallin B chain antibody; CRYA2 antibody; Cryab antibody; CRYAB_HUMAN antibody; Crystallin alpha B antibody; Crystallin alpha polypeptide 2 antibody; CTPP2 antibody; Heat shock 20 kD like protein antibody; Heat shock protein beta 5 antibody; Heat shock protein beta-5 antibody; HspB5 antibody; Renal carcinoma antigen NY REN 27 antibody; Renal carcinoma antigen NY-REN-27 antibody; Rosenthal fiber component antibody
-
宿主:Rabbit
-
反應(yīng)種屬:Human,Mouse,Rat
-
免疫原:Fusion protein of Human CRYAB
-
免疫原種屬:Homo sapiens (Human)
-
標(biāo)記方式:Non-conjugated
-
抗體亞型:IgG
-
純化方式:Antigen affinity purification
-
濃度:It differs from different batches. Please contact us to confirm it.
-
保存緩沖液:-20°C, pH7.4 PBS, 0.05% NaN3, 40% Glycerol
-
產(chǎn)品提供形式:Liquid
-
應(yīng)用范圍:ELISA,WB,IHC
-
推薦稀釋比:
Application Recommended Dilution ELISA 1:2000-1:5000 WB 1:500-1:2000 IHC 1:25-1:100 -
Protocols:
-
儲存條件:Upon receipt, store at -20°C or -80°C. Avoid repeated freeze.
-
貨期:Basically, we can dispatch the products out in 1-3 working days after receiving your orders. Delivery time maybe differs from different purchasing way or location, please kindly consult your local distributors for specific delivery time.
-
用途:For Research Use Only. Not for use in diagnostic or therapeutic procedures.
相關(guān)產(chǎn)品
靶點詳情
-
功能:May contribute to the transparency and refractive index of the lens. Has chaperone-like activity, preventing aggregation of various proteins under a wide range of stress conditions.
-
基因功能參考文獻:
- alphaB-crystallin mutants carrying point substitutions in the C-terminal domain PMID: 28919577
- Heparan sulfate mediates cell uptake of alphaB-crystallin fused to the glycoprotein C cell penetration peptide PMID: 29408057
- Our findings suggest that serum level of miR-491 has potential as a biomarker for predicting OS progression and prognosis of OS patients. miR-491 exerts its role by directly targeting alphaB-crystallin (CRYAB) in OS. PMID: 28648665
- Study identified by a next-generation sequencing panel the novel CRYAB missense mutation c.326A>G, p.D109G in a small family with RCM in combination with skeletal myopathy with an early onset of the disease. PMID: 28493373
- Using a combination of co-sedimentation centrifugation, viscometric assays and electron microscopy of negatively stained filaments to analyse the in vitro assembly of desmin filaments, this study shows that the binding of CRYAB to desmin is subject to its assembly status, to the subunit organization within filaments formed and to the integrity of the C-terminal tail domain of desmin. PMID: 28470624
- Overexpression of both HSPB5 and Hsp27 significantly reduced the intracellular aggregation of alpha-synuclein. PMID: 28337642
- Glutathione-S-transferase - HspB1 fusion protein prevents more aggregation of malate dehydrogenase compared to glutathione-S-transferase -HspB5 fusion protein and wild type HspB1. PMID: 28130664
- Mechanistic studies revealed KLF4 specifically bound the promoter of CRYAB and upregulated CRYAB expression in human osteosarcoma cells. PMID: 27105535
- mRNA levels of HSP family members (HSP70B', HSP72, HSP40/DNAJ, and HSP20/CRYAB) are upregulated by the intracellular MMP3 overload. PMID: 27206651
- HspB5 maybe trigger the epithelial-mesenchymal transition in colorectal cancer (CRC) by activating the ERK signaling pathway. It is a potential tumor biomarker for CRC diagnosis and prognosis. PMID: 28796798
- The CLN6 is not only a molecular entity of the anti-aggregate activity conferred by the ER manipulation using TMalphaBC, but also serves as a potential target of therapeutic interventions. PMID: 28476624
- A missense mutation in alpha B-crystallin that changes proline 20 to an arginine leads to diminished anti-apoptotic activity compared with the native protein. PMID: 28007594
- phosphorylation finely regulates the chaperone activity of CRYAB with multipass TMPs and suggest a pivotal role for S59 in this process PMID: 27641668
- A missense mutation (p.D109G) in CRYAB causes restrictive cardiomyopathy (RCM). PMID: 28493373
- This work examines the molecular mechanism by which two canonical sHsps, alphaB-crystallin (alphaB-c) and Hsp27, interact with aggregation-prone alpha-syn to prevent its aggregation in vitro Both sHsps are very effective inhibitors of alpha-syn aggregation PMID: 27587396
- 343delT/343delT and WT KI/343delT-induced pluripotent stem cell-derived skeletal myotubes and cardiomyocytes did not express detectable levels of 343delT protein, contributable to the extreme insolubility of the mutant protein. Overexpression of HSPB5 343delT resulted in insoluble mutant protein aggregates and induction of a cellular stress response. PMID: 27226619
- Study suggests that wild-type and mutant alphaB-Cry have dissimilar secondary and tertiary structures. Moreover, alphaB-Cry indicates slightly improved chaperone activity upon the R12C mutation. These results may explain to some extent the non-cataractogenic nature of R12C mutation in aB-Cry. PMID: 27260392
- Cryab expression was elevated in osteosarcoma tissues and cell lines, and down-regulation of Cryab in MG-63 and U-2OS cells led to a decline in the cells' aggressiveness, and reduced secretion of matrix metalloproteinase-9 in vitro, and lower metastasis potential in vivo. PMID: 26789112
- Identifies alphaB-crystallin as a new binding partner for Nav1.5. alphaB-Crystallin interacts with Nav1.5 and increases INa by modulating the expression level and internalization of cell surface Nav1.5 and ubiquitination of Nav1.5, which requires the protein-protein interactions between alphaB-crystallin and Nav1.5 and between alphaB-crystallin and functionally active Nedd4-2. PMID: 26961874
- Alpha B-crystalline plays an important regulatory role in exosome biogenesis. PMID: 27129211
- alphaB-crystallin is an important regulator of epithelial-mesenchymal transition, acting as a molecular chaperone for SMAD4 and as its potential therapeutic target for preventing subretinal fibrosis development in neovascular age-related macular degeneration PMID: 26878210
- alpha B crystallin is an independent prognostic factor of infiltrating ductal carcinoma of the breast PMID: 26464626
- two novel missense mutations, p.R11C and p.R12C, in CRYAB associated with autosomal recessive congenital nuclear cataracts. PMID: 26402864
- Phosphorylation of alphaB-crystallin has dual role that manifests either beneficial or deleterious consequences depending on the extent of phosphorylation and interaction with cytoskeleton. [review] PMID: 26415747
- The multifunctional activity of human alphaB crystallin results from the interactive peptide sequences exposed on the surface of the molecule. [review] PMID: 26341790
- Data show that phosphorylation of crystallin alphaB (cryAB) deters its packaging into vesicles for exosomal secretion. PMID: 26620801
- CRYAB protein was up regulated in laryngeal squamous cell carcinoma. PMID: 24817638
- was It is markedly upregulated in the substantia nigra of PD patients where Cryab was present in glial cell inclusions. PMID: 25683516
- A conserved histidine modulates HSPB5 structure to trigger chaperone activity in response to stress-related acidosis. PMID: 25962097
- These data suggest that alphaB-crystallin uses its inherent structural plasticity to expose distinct binding interfaces and thus interact with a wide range of structurally variable clients. PMID: 26458046
- findings point to alphaB-crystallin as a novel regulator of anoikis resistance that is induced by matrix detachment-mediated suppression of ERK signaling and promotes lung metastasis. PMID: 25684139
- Data suggest expression of CRYAB in endometrium in women with endometriosis may be biomarker for subsequent fertility; CRYAB levels in normal range (neither up- nor down-regulated) are indicative of fertility following medical or surgical treatment. PMID: 24945100
- we have summarized current data from emerging and exciting studies of the therapeutic strategies of alpha BC and alpha BC peptides and the efficient delivery strategies of these proteins in various disease models, including neurodegenerative diseases PMID: 25601468
- Study provides an accurate determination of the translational and rotational diffusion of alphaB-crystallin over a wide range of concentrations PMID: 25564856
- Results suggest a limited function of alphaB-crystallin and HSP27 in preventing abnormal tau protein deposition in glial cells and neurons; in addition, the expression of alphaB-crystallin phosphorylated at Ser59 may act as a protective factor in glial cells. PMID: 24985029
- results show that U373 cells produce and secrete CRYAB via exosomes and that stimulation with IL-1beta and TNF-alpha significantly increase the levels of CRYAB in not only the cells but also in the secreted exosomes PMID: 25261722
- CRYAB expression is correlated with substantial clinical characteristics of colorectal carcinoma, and it may be identified as an unfavorable prognostic factor for CRC. PMID: 25337251
- Raising the levels of CRYAB in spinal motor neurons by 6-fold did not delay paralysis in SOD1 transgenic mice. PMID: 25557022
- High expression of CRYAB was correlated with poor survival in non-small cell lung cancer patients. PMID: 25048725
- Mutations in CRYAB protein are a rare cause of genetically determined dilated cardiomyopathy. PMID: 23590293
- Data indicate that alpha-crystallin B chain and beta-crystallin A3-cyrstallins dissociate to the monomers upon racemization of d-aspartic acids (Asp). PMID: 25450505
- Data suggest that inflammatory demyelination during multiple sclerosis is selectively associated with IFN-gamma-induced re-programming of an otherwise protective response of microglia and macrophages to the endogenous TLR2 agonist HSPB5 PMID: 24997049
- alphaB-crystallin hasa role in preventing protein aggregation by manipulation of the ER microenvironment PMID: 25449278
- This study reported a novel c.59C > G (P20R) missense mutation in CRYAB in a five-generation Chinese family with posterior polar cataract. PMID: 25195561
- strong prognostic marker for poor outcome in oral squamous cell carcinoma PMID: 24702231
- The higher expression of alphaB-crystallin may lead to prolonged survival of these cells under hypoxic conditions. PMID: 24725344
- investigated differences in protein expression levels in IDH1(R132H) mutant versus IDH1 wild type grade III gliomas; alphaB-crystallin proteins are elevated in IDH1(R132H) mutant tumors; expression appears to be controlled at post-translational level; most abundant form of alphaB-crystallin is a low molecular weight C-terminally truncated form PMID: 24473683
- Alpha B-crystallin has an essential role in TSC1/2 complex deficiency-mediated tumorigenesis. PMID: 24077282
- These findings provide novel insights into the role of p53 as a regulator of bidirectional gene pair HspB2/alpha B-crystallin-mediated ROS and the Warburg effect PMID: 24859470
- Crystallin alpha-B is increased in DNA microarray assays of papillary thyroid carcinoma PMID: 24880201
顯示更多
收起更多
-
相關(guān)疾病:Myopathy, myofibrillar, 2 (MFM2); Cataract 16, multiple types (CTRCT16); Myopathy, myofibrillar, fatal infantile hypertonic, alpha-B crystallin-related (MFMFIH-CRYAB); Cardiomyopathy, dilated 1II (CMD1II)
-
亞細(xì)胞定位:Cytoplasm. Nucleus. Secreted.
-
蛋白家族:Small heat shock protein (HSP20) family
-
組織特異性:Lens as well as other tissues. Expressed in myocardial tissue.
-
數(shù)據(jù)庫鏈接:
Most popular with customers
-
-
YWHAB Recombinant Monoclonal Antibody
Applications: ELISA, WB, IHC, IF, FC
Species Reactivity: Human, Mouse, Rat
-
Phospho-YAP1 (S127) Recombinant Monoclonal Antibody
Applications: ELISA, WB, IHC
Species Reactivity: Human
-
-
-
-
-